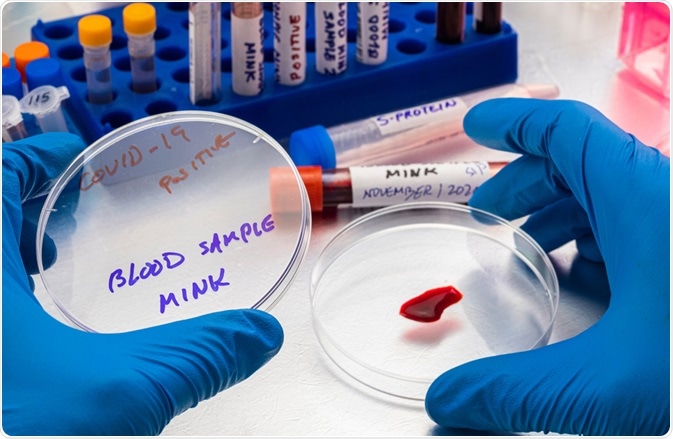
mink covid

A novel coronavirus that was first reported in China in December 2019 quickly led to a global pandemic. Named severe acute respiratory syndrome coronavirus 2 (SARS-CoV-2), the virus causes COVID-19 in humans and has subsequently devastated economies and healthcare systems worldwide.
 Large cats are susceptible to SARS-CoV-2. Image Credit: Milkovasa / Shutterstock.com
Large cats are susceptible to SARS-CoV-2. Image Credit: Milkovasa / Shutterstock.com
Whilst highly contagious between humans, current evidence regarding transmission between animals and humans suggests that animals do not play a significant role in spreading the infection. However, more research is needed to understand how animals are affected by COVID-19 and when human-animal transmission may occur.
SARS-CoV-2 and animals
The coronavirus disease 2019 (COVID-19) pandemic is a current global disease outbreak first identified in December 2019 in Wuhan, China. Subsequently named the severe acute respiratory syndrome coronavirus 2 (SARS-CoV-2), it belongs to a large family of viruses named Coronaviridae.
Some strains belonging to the Coronaviridae family affect humans, such as the Severe Acute Respiratory Syndrome (SARS), some can affect animals such as kennel cough in dogs or feline infectious peritonitis (FIP) in cats. However, some strains can affect both humans and animals.
Coronaviruses are a large family of viruses. Some coronaviruses cause cold-like illnesses in people, while others cause illness in certain animals, such as cattle, camels, and bats. Some coronaviruses, such as canine and feline coronaviruses, infect only animals and do not infect people.
COVID-19 has been classified as a zoonotic disease. A zoonosis is defined as any disease which is naturally communicable between humans and vertebrate animals. Whilst the initial detection of the virus has been pinpointed to the Huanan Seafood Wholesale (Wet) Market, with live purchase and slaughter of over one hundred domestic and wildlife animals, the exact origin is yet to be identified.
However, based on similarities between the current coronavirus and previous similar viruses, it is likely that it originated in either bats or pangolins.
Which animals are susceptible to COVID-19?
Because COVID-19 is zoonotic in origin, it is likely to have the potential to infect animals as well as humans. However, becoming infected with a disease does not necessarily lead to illness or symptom development. Current evidence shows that whilst COVID-19 affects different breeds in different ways. Infection appears to either spread from human to animal or animal to animal.
There is limited evidence that cats and dogs can develop COVID-19 after exposure in the laboratory and naturalistic settings.
Dogs are thought to be at lower risk: when infected, they do not always develop symptoms and when they do, they are mild. Replication of the SARS-CoV-2 virus in dogs is low, and they have low susceptibility to the virus from humans. There is also no evidence that dogs can transmit the virus to other dogs.
Cats, however, are highly susceptible to the virus as SARS-CoV-2 replicates efficiently after infection. The virus appears to replicate in the nose and throat, with further evidence of infection deeper in the respiratory tract, allowing for cat-to-cat airborne transmission. Large cats are also susceptible to infection and can transmit the virus between animals. Cases of lions, tigers and snow leopards with COVID-19 have been reported.
Infection with SARS-CoV-2 has been reported in mink in numerous countries worldwide, including the Netherlands, Italy, Spain, France, Canada and the United States. Image Credit: felipe caparros / Shutterstock.com
Infection with SARS-CoV-2 has been reported in mink in numerous countries worldwide, including the Netherlands, Italy, Spain, France, Canada and the United States. Image Credit: felipe caparros / Shutterstock.com
Mink
Infection with SARS-CoV-2 has been reported in mink in numerous countries worldwide, including the Netherlands, Italy, Spain, France, Canada and the United States. Reports from affected mink farms show an increase in respiratory diseases and deaths, although in some cases, asymptomatic mink from affected farms have also tested positive.
Although COVID-19 is thought to have been introduced to affected farms via infected humans, the virus is transmissible between mink and from mink to other animals.
In November 2020, Denmark reported that over 200 people had become infected with a mink-related coronavirus mutation, caused by an unusual ‘spillback’ whereby mink which have become infected by humans have, in a small number of cases, passed the virus back to humans. When this occurs, small genetic changes to the virus occur, and in the case of some mink-related strains, the protein of the virus is targeted by vaccines.
Following these findings, the Centers for Disease Control and Prevention (CDC) have developed specific guidance for people working on mink farms. Designed to minimize the risk of infection, the guidance includes:
- Restricted access to the premises and buildings where the production of the animals occur
- Employees who have symptoms upon arrival at work or who become sick during the day should immediately be separated from all other people and animals before being sent home, where they should follow current quarantining guidelines.
- Social distancing measures should be robustly and closely adhered to.
- Face coverings should always be worn.
- Handwashing and cleaning of all areas should be regularly undertaken.
Additionally, they have published strict guidelines for the management of mink with suspected COVID-19 infection, including the immediate quarantine of affected farms and identification of epidemiologically linked farms. Following this, there are procedures for reporting infections and sampling to help understand how the virus spread among mink, other animals, and humans.
References
- Andersen, K. G., Rambaut, A., Lipkin, W. I., Holmes, E. C., & Garry, R. F. (2020). The proximal origin of SARS-CoV-2. Nature medicine, 26(4), 450–452. https://doi.org/10.1038/s41591-020-0820-9.
- Gollakner R, Capua I. Is COVID-19 the first pandemic that evolves into a panzootic? Vet Ital. 2020 Apr 24;56(1):7-8. doi: 10.12834/VetIt.2246.12523.1. PMID: 32315124.
- Haider, N., Rothman-Ostrow, P., Osman, A. Y., Arruda, L. B., Macfarlane-Berry, L., Elton, L., Thomason, M. J., Yeboah-Manu, D., Ansumana, R., Kapata, N., Mboera, L., Rushton, J., McHugh, T. D., Heymann, D. L., Zumla, A., & Kock, R. A. (2020). COVID-19-Zoonosis or Emerging Infectious Disease?. Frontiers in public health, 8, 596944. https://doi.org/10.3389/fpubh.2020.596944.
- Oude Munnink, B. B., Sikkema, R. S., Nieuwenhuijse, D. F., Molenaar, R. J., Munger, E., Molenkamp, R., van der Spek, A., Tolsma, P., Rietveld, A., Brouwer, M., Bouwmeester-Vincken, N., Harders, F., Hakze-van der Honing, R., Wegdam-Blans, M., Bouwstra, R. J., GeurtsvanKessel, C., van der Eijk, A. A., Velkers, F. C., Smit, L., Stegeman, A., … Koopmans, M. (2021). Transmission of SARS-CoV-2 on mink farms between humans and mink and back to humans. Science (New York, N.Y.), 371(6525), 172–177. https://doi.org/10.1126/science.abe5901
- Shi J, Wen Z, Zhong G, Yang H, Wang C, Huang B, Liu R, He X, Shuai L, Sun Z, Zhao Y, Liu P, Liang L, Cui P, Wang J, Zhang X, Guan Y, Tan W, Wu G, Chen H, Bu Z. Susceptibility of ferrets, cats, dogs, and other domesticated animals to SARS-coronavirus 2. Science. 2020 May 29;368(6494):1016-1020. doi: 10.1126/science.abb7015. Epub 2020 Apr 8. PMID: 32269068; PMCID: PMC7164390.
Further Reading
Last Updated: Feb 28, 2021